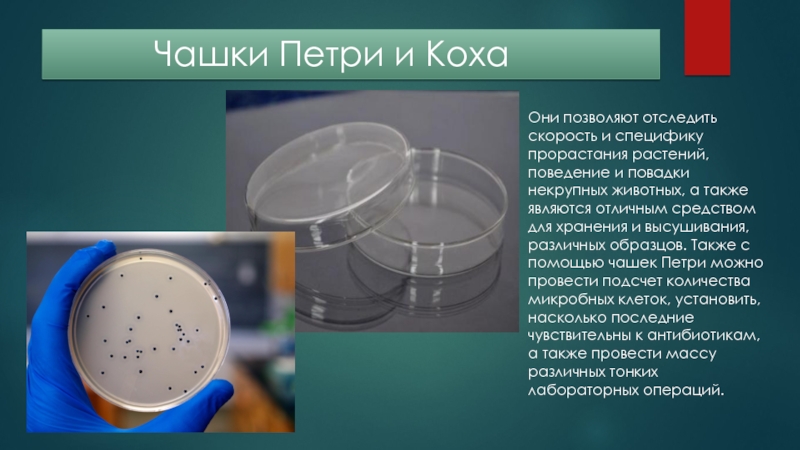

Разделы презентаций
- Разное
- Английский язык
- Астрономия
- Алгебра
- Биология
- География
- Геометрия
- Детские презентации
- Информатика
- История
- Литература
- Математика
- Медицина
- Менеджмент
- Музыка
- МХК
- Немецкий язык
- ОБЖ
- Обществознание
- Окружающий мир
- Педагогика
- Русский язык
- Технология
- Физика
- Философия
- Химия
- Шаблоны, картинки для презентаций
- Экология
- Экономика
- Юриспруденция
Химическая посуда и ее значение
Содержание
- 1. Химическая посуда и ее значение
- 2. Описание !Лабораторная
- 3. Классификация
- 4. Наиболее часто используемые типы лабораторной посудыВоронки лабораторные
- 5. Уход за лабораторной посудой
- 6. Посуда общего назначения
- 7. ОбычнаяГрадуированнаяцентрифужная
- 8. Слайд 8
- 9. Держатель для пробирокШтативы служат для закрепления
- 10. Химические стаканы Химический
- 11. Колба Колба —
- 12. Колбы
- 13. Слайд 13
- 14. Мерная посуда
- 15. Бюретки Бюретка — тонкая
- 16. Слайд 16
- 17. ПипеткаПипетка —
- 18. Фарфоровая посуда
- 19. Фарфоровая посуда
- 20. Ступки , ложки и
- 21. Воронка
- 22. Металлической оборудованиеШтатив с набором держателей
- 23. Газовые горелки Применяютсядля нагревания. Сущесвуют разных форм и различной мощности.
- 24. Посуда специального назначенияКолбы для отсасыванияКолба Бунзена- плоскодонная
- 25. Делительные воронки Делительные воронки
- 26. Холодильник ЛибихаХолодильник — лабораторный прибор
- 27. Колба ВюрцаКолба Вюрца- это
- 28. Чашки
- 29. Без химической посуды люди не могли бы
- 30. Скачать презентанцию
Слайды и текст этой презентации
Слайд 3 Классификация
Посуда общего назначения
– универсальные сосуды, которые могут использоваться для проведения широкого спектра
аналитических работ. Изделия этой категории (колбы, воронки, стаканы, пробирки и пр.) в обязательном порядке присутствуют во всех лабораториях независимо от их профиля.Посуда специального назначения – функциональные сосуды, применяемые для определенных целей. Номенклатура таких изделий (холодильники, тигли, дефлегматоры, делительные воронки, колбы Вюрца, бюксы, капельницы и т. д.) определяется индивидуально для каждой лаборатории в зависимости от специфики ее деятельности.
Мерная посуда – сосуды с градуированной шкалой, предназначенные для измерения объема жидких веществ. К этой категории относятся мерные цилиндры, колбы, пипетки, пробирки.
Слайд 4Наиболее часто используемые типы лабораторной посуды
Воронки лабораторные
Колбы: с широким
или узким горлом, плоскодонные или круглодонные
Колпаки для накрывания образцов
и приборов.Пробирки
Стаканы
Чашки Петри и Коха
Бюретки
Подставки для пробирок.
Пипетки
Слайд 5 Уход за лабораторной посудой
Постоянная очистка сосудов от загрязнений
осуществляется механическим путем с помощью теплой воды, ершей, щеток. Некоторые
осадки удаляются растворителями. Сложные загрязнения удаляются специальными смесями и моющими растворами. Остатки моющих средств на поверхности сосудов могут испортить результаты исследований, поэтому после удаления загрязнений необходимо многократно промыть изделие водой. Сосуды моют вручную либо в специальных машинах . В крупных лабораториях для мытья большого количества посуды используют ультразвуковые установки и автоматизированные сушильные шкафы.Слайд 6Посуда общего назначения
Пробирка
Пробирки – узкие стеклянные
сосуды цилиндрической формы, нижний край которых закруглен. Используется для проведения химический реакций в небольших объемах, для отбора веществ.
Чаще всего изготавливается из специального лабораторного стекла иногда из кварцевого стекла, а также из пластика Поверхность пробирок иногда обрабатывается антимикробными веществами и веществами
Слайд 8
Для хранения пробирок
находящихся в работе существуют специальные штативы
пластмассовые
деревянные
металлические
Слайд 9 Держатель для пробирок
Штативы служат для закрепления на них всякого
рода приборов.
Ухватики. Вместо тигельных щипцов часто
удобнее пользоваться ухватиками, размеры которых подгоняют к размерам тиглей, применяемых в лаборатории. Используется при нагревании
пробирок с веществами, чтобы
не касаться раскаленного
стекла.
Слайд 10 Химические стаканы
Химический стакан — вид
лабораторной посуды, тонкостенная цилиндрическая ёмкость с плоским дном.
Бывают :с носиком
и без носика
Иногда на стаканы нанесена измерительная шкала.
Химические стаканы используются обычно для приготовления растворов сложного состава, когда необходимо при перемешивании растворять несколько твёрдых веществ.
Слайд 11 Колба
Колба — стеклянный сосуд с
круглым или плоским дном, обычно с узким длинным горлом. Разновидность
технических сосудов, применяемых в химических лабораториях. Существуют мерные колбы, колбы-реакторы и колбы-приемники. А также плоскодонные, круглодонные и остродонные.Колбы применяются в лабораториях в качестве реакционных сосудов. Существуют также специальные мерные колбы для приготовления с высокой точностью аналитических растворов.
Слайд 13 Воронка
Воронка- приспособление
для переливания жидкостей.
Более сложные виды воронок используются в промышленности
и в лабораторной технике для фильтрования, разделения жидкостей и других целей.Воронки бывают:
Различных размеров
Для фильтрования
Обычные
Слайд 14 Мерная посуда
Измерительные цилиндры
Мензурка— вид лабораторной посуды, стеклянный конический или цилиндрический лабораторный
стакан с делениями и носиком, применяемый в лабораториях для измерения объёмов жидкостей.Мензурки могут также применяться для отстаивания мутных жидкостей, при этом осадок собирается в нижней суженной части.
Градуировка различается в зависимости от типа изделия: мензурки, мерные цилиндры и пробирки обычно имеют нанесённую снаружи измерительную шкалу, мерные колбы обычно имеют лишь одну или две отметки на цилиндрической части.
Слайд 15 Бюретки
Бюретка — тонкая градуированная стеклянная трубка,
открытая на одном конце и снабжённая стеклянным или тефлоновым запорным
краном на другом. Предназначена для измерения определённого количества жидкости.Бюретками измеряют объёмы
жидкостей при титровании.
Титрование- метод
количественного/массового
анализа.
Слайд 16 Термометр
Термометр — прибор
для измерения температуры воздуха, почвы, воды и так далее. Существует
несколько видов термометров:жидкостные;
механические;
электронные;
оптические;
газовые;
инфракрасные.
Слайд 17 Пипетка
Пипетка — мерный или дозирующий
сосуд, представляющий собой трубку, либо ёмкость с трубкой, имеющую конец
(наконечник, кончик, носик) с небольшим отверстием, для ограничения скорости вытекания жидкости.Разнообразные пипетки широко применяются для отмеривания точных объёмов жидкостей или газов, в медицине, химии и биологии, а особенно широко — в аналитической химии и биохимии.
Чаще всего это стеклянный сосуд, применяемый для точного измерения (дозирования) объёма жидкости.
Выпускают различные типы мерных пипеток для самых разных целей, с различными классами точности и на разные объёмы.
Слайд 18 Фарфоровая посуда
Основное преимущество фарфора
по сравнению со стеклом- термостойкость и механическая прочность. Твердый фарфор,
из которого изготовляют лабораторную посуду (без покрытия глазурью), выдерживает нагревание до 1300С; фарфор, покрытый глазурью, размягчается при 1200С.Фарфоровая посуда делится на:
Чашки
Ступки и пестики
Шпатели и ложки
Воронки
Тигли
Кружки
И у всех есть свое предназначение , которое играет немалую роль при работе с химическими реакциями.
Слайд 19 Фарфоровая посуда
чашки, тигли
Чашка
в Тигель
Фарфоровая чашка - для выпаривания.
А тигель для прокаливания различных материалов, выпаривания растворов, определения зольности органических веществ и др.
Слайд 20 Ступки , ложки и шпатели
Ступки применяются
Ложки и шпатели используются для измельчения для отбора веществ и снятия
твердых веществ. осадков с фильтров.
Слайд 21 Воронка Бюхнера
Предназначена для фильтрования
под вакуумом, традиционно выполняется чаще всего из фарфора, реже —
из металла или пластмасс. Верхняя часть воронки, в которую наливают жидкость, пористой или перфорированной перегородкой отделена от нижней части, к которой подведён вакуум.Слайд 22 Металлической оборудование
Штатив с набором держателей
(лапок, колец и
муфт)
Необходим для закрепленияприборов и различной посуды
Слайд 24Посуда специального назначения
Колбы для отсасывания
Колба Бунзена- плоскодонная коническая колба из
толстостенного стекла с тубусом (отводом). Колбы Бунзена применяются в основном
для вакуумного фильтрования.Используется колба Бунзена в основном для вакуумного фильтрования, в котором эта колба служит сборником фильтрата. Колба Бунзена может быть использована и для других целей, например, для получения газов при химических реакциях, а также как предохранительный сосуд при вакуумных процессах.
Слайд 25 Делительные воронки
Делительные воронки - это удлиненный
цилиндрический или грушевидный сосуд, применяемый чаще всего для разделения несмешивающихся
жидкостей Трубка у делительных воронок может быть короткой и несколько удлиненной в зависимости от условий использования, но диаметр трубки должен быть таким, чтобы жидкость в ней не задерживалась.Слайд 26 Холодильник Либиха
Холодильник — лабораторный прибор для конденсации паров
жидкостей при перегонке или нагревании . Используют для отгонки растворителей
из реакционной среды, для разделения смесей жидкостей на компоненты или для очистки жидкостей перегонкой.В зависимости от способа применения различают следующие типы холодильников:
Прямой холодильник - применяется для конденсирования паров и отвода образовавшегося конденсата из реакционной системы. Сбор конденсата ведется в колбу-приемник.
Обратный холодильник - применяется для конденсирования паров и возврата конденсата в реакционную массу.
Слайд 27 Колба Вюрца
Колба Вюрца- это круглодонные колбы с
длинным горлом, от которого отходит под углом длинная узкая отводная
трубка.Используется для перегонки при атмосферном давлении. Колба Вюрца закрепляется через резиновое или силиконовое кольцо на лапке штатива, при перегонке колбу Вюрца нагревают на открытом пламени горелки . В отвод колбы вставляется прямоточный холодильник Либиха. В резиновую пробку вставляют термометр для измерения температуры кипения перегоняемой жидкости.
Слайд 28 Чашки Петри и Коха
Они
позволяют отследить скорость и специфику прорастания растений, поведение и повадки
некрупных животных, а также являются отличным средством для хранения и высушивания, различных образцов. Также с помощью чашек Петри можно провести подсчет количества микробных клеток, установить, насколько последние чувствительны к антибиотикам, а также провести массу различных тонких лабораторных операций.Слайд 29Без химической посуды люди не могли бы проводить столь точные
и интересные опыты и реакции.
Не было бы такого развития науки,
как в наше время. Благодаря все этой посуде люди сделали немало открытий, и нашли много способов излечения всевозможных болезней .Прогресс не останавливается и люди до сих пор придумывают разную посуду и приспособления для изучения науки- химии. Но порой до сегодняйшего дня в работе используется химическая посуда, придуманная в давние времена.